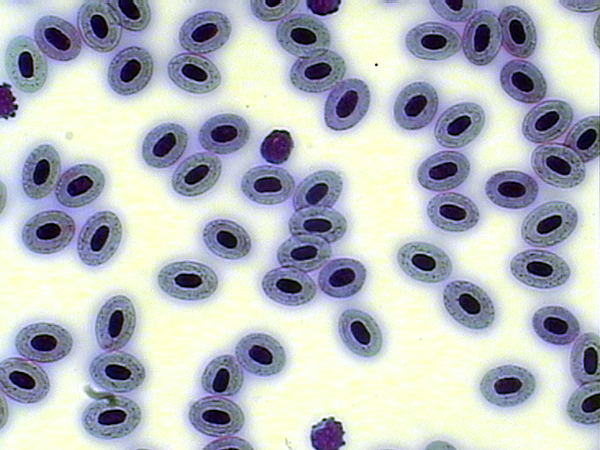

Salmotrip: Feasibilty study of Triploid Atlantic Salmon Production 2008-2010
Diploid

Triploid
The negative environmental impact of escapees from fish farms is a general concern among the salmon industry and authorities. Using sterile (Triploid) fish in culture has been proposed to reduce this problem considerably.
Triploidy also offers several other advantages: no maturation (at least in females, males still developing gonads) = improved flesh quality at harvest, wider harvest windows, lowered disease risk, reduced running cost as lights may not be required anymore and a means for breeding companies to protect IPR on selected strains. Sterility can be induced at the egg fertilisation stage by hydrostatically shocking eggs (see picture on the right) to produce offspring with an extra chromosome set (Triploid) and no gonadal development.

Triploid Induction Process
Triploidy was tried in the early 90's but encountered numerous problems (poor growth and survival, and increased deformity rate) and the concept was abandoned. Nonetheless, triploid salmon has the potential to make an important contribution towards a more sustainable and environmentally friendly salmon industry. However, prior to implementing such a radical change within the industry, a sounder understanding of triploid requirements and performances is needed at a commercial scale.
As a result a trans-national collaborative project supported by 5 key players of the salmon industry and 3 research centres was started in June 2008 as part of the EU 7th Framework Programme. The project focuses on 5 key areas regarding the evaluation and optimisation of triploid salmon production. Only when this knowledge is available and consumer perception addressed can the potential for triploidy be realised as a viable farming option for the industry.
